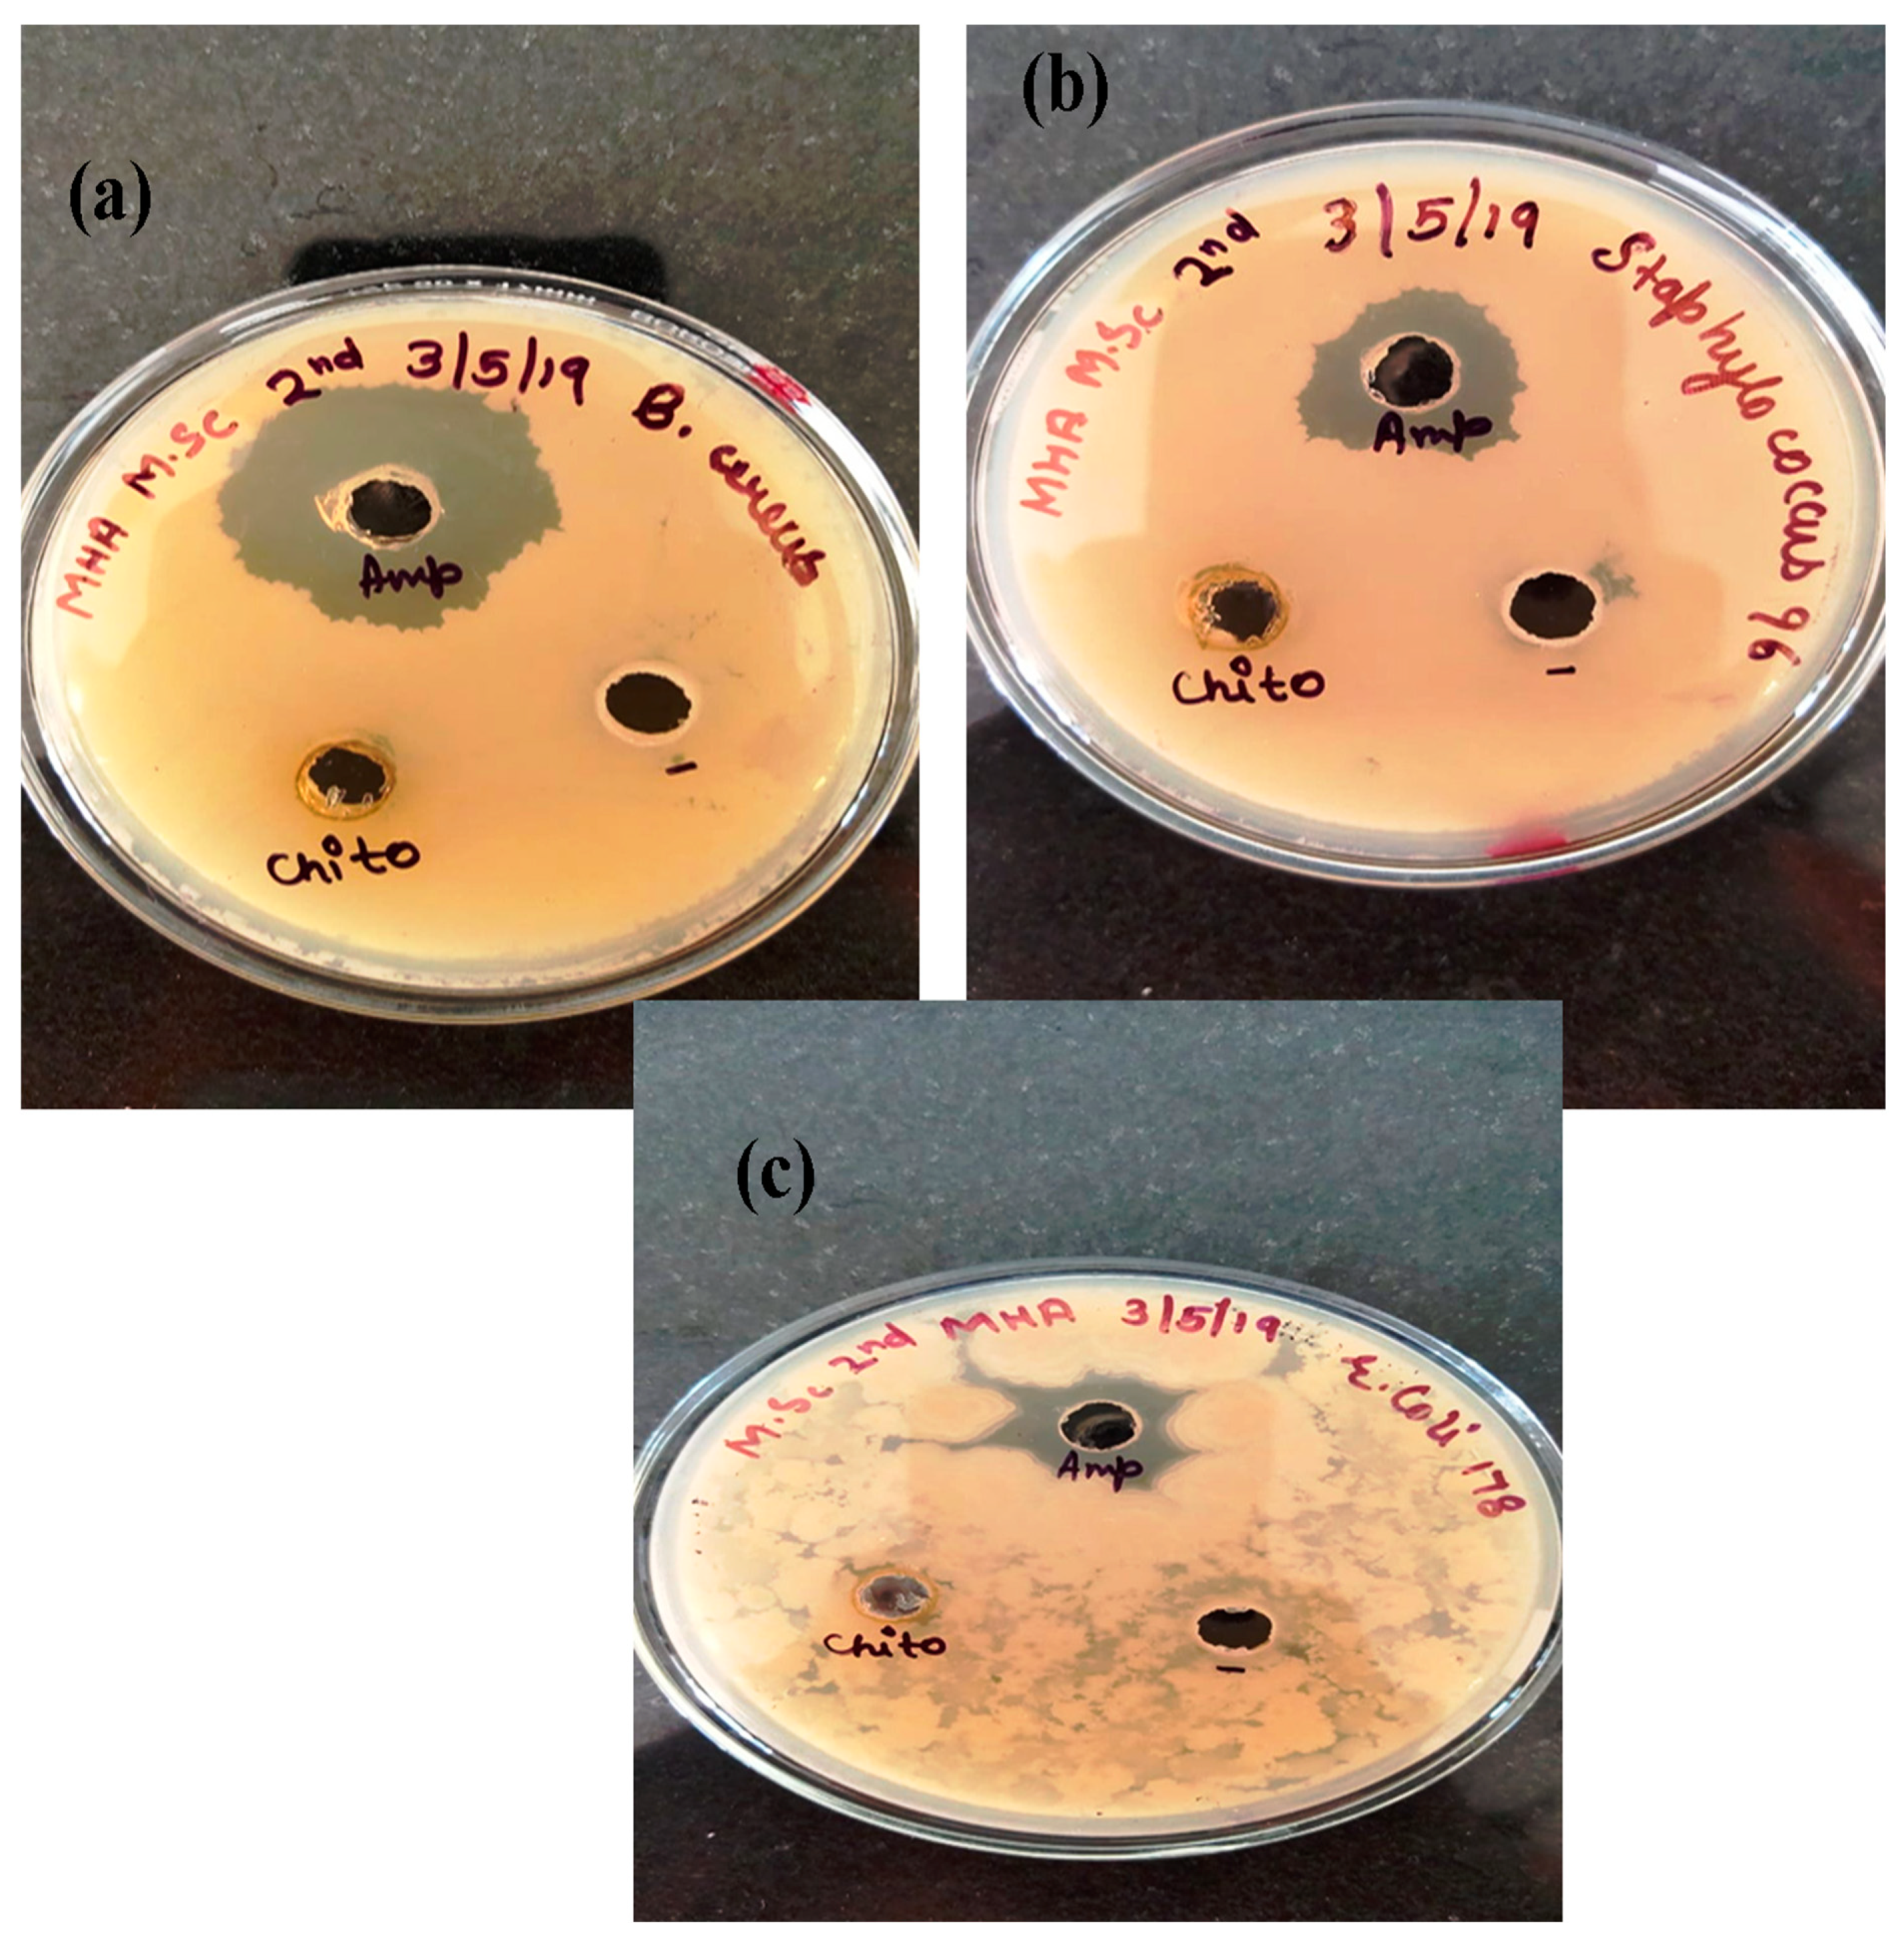
Polymers 14 01911 g010 550

A Green Approach for the Synthesis of Silver Nanoparticle-Embedded Chitosan Bionanocomposite as a Potential Device for the Sustained Release of the Itraconazole Drug and Its Antibacterial Characteristics
Abstract
:1. Introduction
2. Materials and Methods
2.1. Materials
2.2. Methods
2.2.1. Preparation of Sugarcane Extract
2.2.2. Green Synthesis of AgNPs
2.2.3. Synthesis of AgNP-Embedded Chitosan (CH-Ag) Bionanocomposite
2.3. Characterization of AgNPs
2.4. Drug Loading
- Incorporation of the drug at the time of nanoparticle synthesis;
- Imbibing the drug after the formation of nanoparticles.
2.5. In Vitro Drug Release Studies
2.6. Mechanism of Drug Release
2.7. Kinetics of Drug Release
3. Results and Discussion
3.1. Characterization
3.1.1. TEM Analysis
3.1.2. FTIR Analysis of Synthesized AgNPs
3.1.3. Visual Observation
3.2. Drug Loading and Release Studies
3.3. Antibacterial Activity of AgNPs and CH-Ag Bionanocomposite
4. Conclusions
Author Contributions
Funding
Data Availability Statement
Acknowledgments
Conflicts of Interest
References
- Matteis, V.D.; Rizzello, L.; Ingrosso, C.; Liatsi-Douvitsa, E. Cultivar-Dependent Anticancer and Antibacterial Properties of Silver Nanoparticles Synthesized Using Leaves of DifferentEuropaea Trees. Nanomaterials 2019, 9, 1544. [Google Scholar] [CrossRef] [PubMed] [Green Version]
- Naushad, M.; ALOthman, Z.A. Separation of toxic Pb2+ metal from aqueous solution using strongly acidic cation-exchange resin: Analytical applications for the removal of metal ions from pharmaceutical formulation. Desalin. Water Treat. 2015, 53, 2158–2166. [Google Scholar] [CrossRef]
- Saruchi; Thakur, P.; Kumar, V. Kinetics and thermodynamic studies for removal of methylene blue dye by biosynthesize copperoxide nanoparticles and its antibacterial activity. J. Environ. Health Sci. Eng. 2019, 28, 367–376. [Google Scholar]
- Sethi, S.; Kaith, B.S.; Saruchi, K.V. Fabrication and characterization of microwave assisted carboxymethyl cellulose-gelatin silver nanoparticles imbibed hydrogel: Its evaluation as dye degradation. React. Funct. Polym. 2019, 142, 134–146. [Google Scholar] [CrossRef]
- Naushad, M. Surfactant assisted nano-composite cation exchanger: Development, characterization and applications for the removal of toxic Pb2+ from aqueous medium. Chem. Eng. J. 2014, 235, 100–108. [Google Scholar] [CrossRef]
- Saruchi; Kumar, V. Effective degradation of rhodamine B and congo red dyes over biosynthesized silver nanoparticles-imbibed carboxymethylcellulose hydrogel. Polym. Bull. 2020, 77, 3349–3365. [Google Scholar] [CrossRef]
- Ahmad, M.B.; Lim, J.J.; Shameli, K.; Ibrahim, N.A.; Tay, M.Y. Synthesis of Silver Nanoparticles in Chitosan, Gelatin and Chitosan/Gelatin Bionanocomposites by a Chemical Reducing Agent and Their Characterization. Molecules 2011, 16, 7237–7248. [Google Scholar] [CrossRef] [Green Version]
- Balasubramani, K.; Sivarajasekar, N.; Naushad, M. Effective adsorption of antidiabetic pharmaceutical (metformin) from aqueous medium using graphene oxide nanoparticles: Equilibrium and statistical modelling. J. Mol. Liq. 2020, 301, 112426. [Google Scholar] [CrossRef]
- Hwi, J.K.; Lestner, J.J.; Hope, W.W. Itraconazole: Recent update on pharmacology and clinical use for treatment of invasive and allergic fungal infections. Expert Opin. Drug Metab. Toxicol. 2013, 9, 11–926. [Google Scholar]
- Kumar, P.; Gnanajobitha, G.; Vanaja, M.; Pavunraj, M.; Annadurai, G. Green synthesis of silver nanoparticles and silver based chitosan bionanocomposite using stem extract of sugar cane and assessment of its antibacterial activity. Adv. Nat. Sci. Nanosci. Nanotechnol. 2017, 8, 1–9. [Google Scholar]
- Kaith, B.S.; Jindal, R.; Kapur, G.S. Synthesis of acrylic acid based hydrogel: Its evaluation for controlled release of antiulcerative drug pantoprazole sodium. J. Chin. Adv. Mater. Soc. 2014, 1, 63–69. [Google Scholar]
- Naushad, M.; Sharma, G.; Alothman, Z.A. Photodegradation of toxic dye using Gum Arabic-crosslinked-poly(acrylamide)/Ni(OH)2/FeOOH nanocomposites hydrogel. J. Clean. Prod. 2019, 241, 118263. [Google Scholar] [CrossRef]
- Naushad, M.; Mittal, A.; Rathore, M.; Gupta, V. Ion-exchange kinetic studies for Cd(II), Co(II), Cu(II), and Pb(II) metal ions over a composite cation exchanger. Desalin. Water Treat. 2015, 54, 2883–2890. [Google Scholar] [CrossRef]
- Abdelhamid, H.N.; El-Ber, H.M.; Metwally, A.A.; Elshazl, M.; Hathout, R.M. Synthesis of CdS-modified chitosan quantum dots for the drug delivery of Sesamol. Carbohdrate Polym. 2019, 214, 90–99. [Google Scholar] [CrossRef] [PubMed]
- Bhumkar, D.R.; Joshi, H.M.; Sastry, M.; Pokharkar, V.B. Chitosan reduced gold nanoparticles as novel carriers for transmucosal delivery of insulin. Pharm. Res. 2007, 24, 1415–1426. [Google Scholar] [CrossRef] [PubMed] [Green Version]
- Bagherzade, G.; Tavakoli, M.M.; Namaei, M.H. Green synthesis of silver Nanoparticles using aqueous extract of saffron (Crocussativus L.) wastages and its antibacterial activity against six bacteria. Asian Pac. J. Trop. Biomed. 2017, 7, 227–233. [Google Scholar] [CrossRef]
- Gopinath, V.; Priyadarshini, S.; Loke, M.F.; Kumar, J.K.; Marsili, E.; Ali, D.M.; Velusamy, P.; Vadivelu, J. Biogenic synthesis, characterization of antibacterial silver nanoparticles and its cell cytotoxicity. Arab. J. Chem. 2017, 10, 1107–1117. [Google Scholar]
- Li, S.; Shen, Y.; Xie, A.; Yu, X.; Qiu, L.; Zhang, L.; Zhang, Q. Green synthesis of silver nanoparticles using Capsicum annuum L. extract. Green Chem. 2007, 9, 852–885. [Google Scholar] [CrossRef]
- Roy, A. Synthesis of silver nanoparticles and its biological application: A review. Res. Rev. Biosci. 2017, 12, 138. [Google Scholar]
- Sharma, G.; Pathania, D.; Naushad, N.; Kothiyal, N.C. Fabrication, characterization and antimicrobial activity of polyaniline Th (IV) tungstomolybdophosphate nanocomposite material: Efficient removal of toxic metal ions from water. Chem. Eng. J. 2014, 251, 413–421. [Google Scholar] [CrossRef]
- Hanna, D.H.; Saad, G.R. Encapsulation of ciprofloxacin with in modified xanthan gum-chitosan based hydrogel for drug delivery. Bioorganic Chem. 2019, 84, 115–124. [Google Scholar] [CrossRef] [PubMed]
- Wang, Y.; Wanga, W.W.; Wanga, W.A. Efficient adsorption of methylene blue on an alginate-based nanocomposite hydrogel enhanced by organo-illite/smectiteclay. Chem. Eng. J. 2013, 228, 132–139. [Google Scholar] [CrossRef]
- Sethi, S.; Kaith, B.S.; Kaur, M.; Sharma, N.; Khullar, S. Study of a Cross-Linked Hydrogel of Karaya Gum and Starch as a Controlled Drug Delivery System. J. Biomater. Sci. 2019, 30, 1687–1708. [Google Scholar] [CrossRef] [PubMed]
- Saruchi; Sharma, M.; Hatshan, M.R.; Kumar, V.; Rana, A. Sequestration of Eosin Dye by Magnesium (II)-Doped Zinc Oxide Nanoparticles: Its Kinetic, Isotherm, and Thermodynamic Studies. J. Chem. Eng. Data. 2021, 66, 646–657. [Google Scholar] [CrossRef]
- Shafaghi, S.; Moghadam, P.M.; Fareghi, A.R.; Baradarani, M.M. Synthesis and characterization of a drug-delivery system based on melamine-modified poly(vinylacetate-co-maleicanhydride) hydrogel. J. Appl. Sci. 2014, 131, 40389. [Google Scholar] [CrossRef]
- Prabaharan, M. Review paper: Chitosan derivatives as promising materials for controlled drug delivery. J. Biomter Appl. 2008, 23, 5–36. [Google Scholar] [CrossRef] [PubMed]
- Sharma, G.; Naushad, N.; Pathania, D.; Mittal, A.; Eldesoky, G.E. Modification of Hibiscus cannabinus fiber by graft copolymerization: Application for dye removal, Desalin. Water Treat. 2015, 54, 3114–3121. [Google Scholar] [CrossRef]
- Keller, B.L.; Lohmann, C.A.; Kyeremateng, S.O.; Fricker, G. Synthesis and Characterization of Biodegradable Poly(butylcyanoacrylate) for Drug Delivery Applications. Polymers 2022, 14, 998. [Google Scholar] [CrossRef]
- Srikhao, N.; Kasemisiri, P.; Lorwanishpaisam, N.; Okhawilai, M. Green synthesis of silvern anoparticles using sugarcane leaves extract for colorimetric detection of ammonia and hydrogenperoxide. Res. Chem. Intermed. 2021, 447, 1–15. [Google Scholar]
- Sethi, S.; Saruchi, K.B.S.; Kaur, M.; Sharma, N.; Kumar, V. Cross-linked xanthan gum–starch hydrogels as promising materials for controlled drug delivery. Cellulose 2020, 47, 4565–4589. [Google Scholar] [CrossRef]
- Kaith, B.S.; Saruchi, J.R.; Bhatti, M.S. Screening and RSM optimization for synthesis of a gum tragacanth–acrylic acid based device for in situ controlled cetirizine dihydrochloride release. Soft Matter 2012, 8, 2286–2293. [Google Scholar] [CrossRef]
- Zhou, H.Y.; Zhang, Y.P.; Zhang, W.F.; Chen, X.G. Biocompatibility and characteristics of injectable chitosan-based thermosensitive hydrogel for drug delivery. Carbohydr. Polym. 2011, 83, 1643–1651. [Google Scholar] [CrossRef]
- Saruchi; Kaith, B.S.; Jindal, R.; Kumar, V.; Bhatti, M.S. Optimal response surface design of Gum tragacanth-based poly[(acrylicacid)-coacrylamide ]IPN hydrogel for the controlled release of the antihypertensive drug losartan potassium. RSC Adv. 2014, 14, 39822–39829. [Google Scholar] [CrossRef]
- Singh, B.; Kumar, A. Network formation of MoringaOleifera gum by radiation induced crosslinking:Evaluation of drug delivery, network parameters and biomedical parameters. Int. J. Biol. Macromol. 2018, 108, 477–488. [Google Scholar] [CrossRef]
- Singh, B.; Sharma, V. Influence of polyme r network parameters of tragacanth gum-based pH responsive hydrogels on drugdelivery. Carbohydr. Polym. 2014, 101, 928–940. [Google Scholar] [CrossRef]
- Singh, B.; Sharma, V. Crosslinking of poly(vinylpyrrolidone)/acrylic acid with tragacanth gum for hydrogels formation for use in drug delivery applications. Carbohydr. Polym. 2017, 157, 185–195. [Google Scholar] [CrossRef]
- Treesuppharata, P.; Rojanapanthua, C.; Siangsanohb, H.; Manuspiyac, S. Synthesis and characterization of bacterial cellulose and gelatin-based hydrogel composites for drug-delivery systems. Biotechnol. Rep. 2017, 15, 84–91. [Google Scholar] [CrossRef]
- Wei, W.; Li, J.; Qi, X.; Zhong, Y.; Zuo, G.; Su, T.; Zhang, J. Synthesis and characterization of a multisensitive polysaccharides hydrogel for drug delivery. Carbohydr. Polym. 2017, 177, 275–283. [Google Scholar] [CrossRef]
- Liu, Y.; Sui, Y.; Liu, C.; Liu, C.; Wu, M.; Li, B.; Li, Y. A physically crosslinked polydopamine/nanocellulose hydrogel as potential versatile vehicles for drug delivery and wound healing. Carbohydr. Polym. 2018, 188, 27–36. [Google Scholar] [CrossRef]
- Shakeel, A.; Mudasir, A. A review on plant extract mediated synthesized of silver nanoparticles for antimicrobial application: A green expertise. J. Adv. Res. 2016, 7, 1. [Google Scholar]
- Weitz, I.S.; Maoz, M.; Panitz, D.; Eichler, S.; Segal, E. Combination of CuO nanoparticles and fluconazole: Preparation, characterization, and antifungal activity against Candida albicans. J. Nanopart. Res. 2015, 17, 119. [Google Scholar] [CrossRef]
- Wan, G.; Ruan, L.; Yin, Y.; Yang, T.; Ge, M.; Cheng, X. Effect of Silver Nanoparticles in combination with antibiotiotics on the resistant bacteria Acinetobacterbaumannii. Int. J. Nanomed. 2016, 11, 3789–3800. [Google Scholar] [CrossRef] [PubMed] [Green Version]
- Usman, M.S.; Zowalaty, M.E.E.; Shameli, K.; Zainuddin, N.; Salama, M.; Ibrahim, N.A. Synthesis, characterization and antimicrobial properties of copper nanoparticles. Int. J. Nanomed. 2013, 8, 4467–4479. [Google Scholar]
- Tiwari, D.K.; Behari, J.; Sen, P. Time and dose-dependent antimicrobial potential of Ag nanoparticles synthesized by top-down approach. Curr. Sci. 2008, 95, 647–655. [Google Scholar]
- Thati, V.; Roy, A.S.; Prasad, A.N.; Shivannavar, C.T.; Gaddad, S.M. Nanostructured zinc oxide enhances the activity of antibiotics against Staphylococcus aureus. J. Biosci. Tech. 2010, 1, 64–69. [Google Scholar]
- Sanpui, P.A.; Murugadoss, P.; Prasad, S.; Ghosh, A.; Chattopadhyay, B. The antibacterial properties of a novel chitosan-Ag-nanoparticle composite. Int. J. Food Microbiol. 2008, 124, 142–146. [Google Scholar] [CrossRef]
- Ezzat, H.; Rady, M.; Hathout, M.R.; Abdel-Halim, M.; Mansour, S. Enhanced anti-bacterial effect of kojic acid using gelatinized coreliposomes: A potential approach to combat antibiotic resistance. J. Drug Deliv. Sci. Technol. 2021, 64, 102625. [Google Scholar] [CrossRef]
- Abdelhamid, S.M.; El-Hasseiny, L.S. Combined efficacy of thymol and silver nanoparticle against Staphylococcus Aureus. Afr. J. Microbiol. Res. 2017, 11, 450–457. [Google Scholar]
- Rozhin, A.; Batasheva, S.; Kruychkova, M.; Cherednichenko, Y.; Rozhina, E.; Fakhrullin, R. Biogenic silver nanoparticles: Synthesis and application as antibacterial and antifungal agents. Micromachines 2021, 12, 1480. [Google Scholar] [CrossRef]
- Singh, M.; Kumar, M.; Kalaivani, R.; Kumaraguru, A.K. Metallic silver nanoparticle: A therapeutic agent in combination with antifungal drug against human fungal pathogen. Bioprocess Biosyst Eng. 2013, 36, 407–415. [Google Scholar] [CrossRef]

| Time (h) | Absorbance |
|---|---|
| 0 | 0.356 |
| 1 | 0.569 |
| 2 | 0.781 |
| 3 | 0.954 |
| 4 | 1.114 |
| 5 | 1.217 |
| 6 | 1.423 |
| 7 | 1.586 |
| 8 | 1.715 |
| 9 | 1.8 |
| 10 | 1.892 |
| 11 | 1.915 |
| 12 | 1.937 |
| Drugs | pH 2 | pH 7 | pH 9.2 |
|---|---|---|---|
| Drug Entrapment Efficiency (EE) % | |||
| Itraconazole | 64.12 ± 0.10 | 94.56 ± 0.11 | 75.03 ± 0.09 |
| Drug | pH | Drug Release (mg) Itraconazole | ‘n’ | ‘k’ | Diffusion Coefficient (cm2h−1) | Mechanism | |||
|---|---|---|---|---|---|---|---|---|---|
| Initial | Final | Di | DA | DL | |||||
| Itraconazole | 2 | 0.75 | 9.2 | 0.462 | 1.431 | 0.176 | 0.021 | 0.08 | Fickian |
| 7 | 1.14 | 14.3 | 1.064 | 1.256 | 0.329 | 0.189 | 0.094 | Non-Fickian | |
| 9.2 | 0.89 | 11.45 | 0.492 | 1.123 | 0.297 | 0.079 | 0.091 | Fickian | |
| Drug | Kinetic Model | pH 2 | pH 7 | pH 9.2 | |
|---|---|---|---|---|---|
| Itraconazole | Zero order | R2 | 0.769 | 0.929 | 0.842 |
| k0 (mg h−1) | 0.102 | 0.181 | 0.135 | ||
| First order | R2 | 0.994 | 0.999 | 0.997 | |
| k1 (h−1) | 0.163 | 0.192 | 0.187 | ||
| Higuchi | R2 | 0.936 | 0.954 | 0.949 | |
| k2 (h−1/2) | 0.489 | 0.672 | 0.598 | ||
| Korsmeyer–Peppas | R2 | 0.967 | 0.993 | 0.982 | |
| k3 (h−n) | 0.479 | 0.596 | 0.501 | ||
| Hixson–Crowell | R2 | 0.714 | 0.798 | 0.752 | |
| k4 (h−1/3) | 0.132 | 0.167 | 0.149 |
Publisher’s Note: MDPI stays neutral with regard to jurisdictional claims in published maps and institutional affiliations. |
© 2022 by the authors. Licensee MDPI, Basel, Switzerland. This article is an open access article distributed under the terms and conditions of the Creative Commons Attribution (CC BY) license (https://creativecommons.org/licenses/by/4.0/).
Share and Cite
Saruchi; Kaur, M.; Kumar, V.; Ghfar, A.A.; Pandey, S. A Green Approach for the Synthesis of Silver Nanoparticle-Embedded Chitosan Bionanocomposite as a Potential Device for the Sustained Release of the Itraconazole Drug and Its Antibacterial Characteristics. Polymers 2022, 14, 1911. https://doi.org/10.3390/polym14091911
Saruchi, Kaur M, Kumar V, Ghfar AA, Pandey S. A Green Approach for the Synthesis of Silver Nanoparticle-Embedded Chitosan Bionanocomposite as a Potential Device for the Sustained Release of the Itraconazole Drug and Its Antibacterial Characteristics. Polymers. 2022; 14(9):1911. https://doi.org/10.3390/polym14091911
Chicago/Turabian StyleSaruchi, Manpreet Kaur, Vaneet Kumar, Ayman A. Ghfar, and Sadanand Pandey. 2022. "A Green Approach for the Synthesis of Silver Nanoparticle-Embedded Chitosan Bionanocomposite as a Potential Device for the Sustained Release of the Itraconazole Drug and Its Antibacterial Characteristics" Polymers 14, no. 9: 1911. https://doi.org/10.3390/polym14091911
APA StyleSaruchi, Kaur, M., Kumar, V., Ghfar, A. A., & Pandey, S. (2022). A Green Approach for the Synthesis of Silver Nanoparticle-Embedded Chitosan Bionanocomposite as a Potential Device for the Sustained Release of the Itraconazole Drug and Its Antibacterial Characteristics. Polymers, 14(9), 1911. https://doi.org/10.3390/polym14091911

